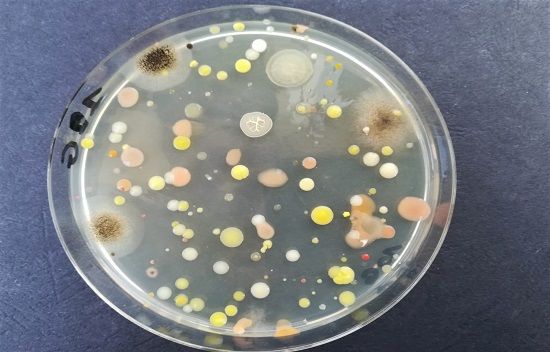

La sanificazione quotidiana riduce dell’85% la probabilità di lavorare in ambienti insalubri.
I risultati di un esperimento realizzato da Pasa Labs
Pasa Labs, società milanese attiva nel settore delle analisi chimiche, fisiche e microbiologiche, ha realizzato un esperimento per valutare in condizioni reali l’efficacia delle pratiche di igienizzazione attuate negli uffici.
I tecnici biologi di Pasa Labs hanno raccolto decine di campioni da postazioni di lavoro differenti, per valutare la presenza di muffe e batteri.
Nel primo caso, l’analisi è stata effettuata in un ambiente lavorativo non igienizzato.
Su 24 postazioni analizzate, il 50% presentava cariche batteriche e micotiche oltre i limiti di riferimento tanto per quanto riguardava l’aria quanto le superfici di lavoro (scrivanie, computer, pareti, maniglie…).
Il secondo set di analisi è stato effettuato in un ambiente di lavoro sottoposto a pratiche di igienizzazione quotidiane.
Su 40 postazioni, solamente 3, corrispondenti al 7,5%, presentavano dei valori fuori norma, relativi peraltro unicamente alla carica batterica.
“Si tratta di un risultato significativo – spiega Annalisa Gussoni, Direttore Tecnico Pasa Labs – perché dimostra l’importanza delle attività di igienizzazione. Inoltre, la nostra analisi mostra anche quanto sia necessario un monitoraggio continuo delle procedure di sanificazione. Anche nel secondo caso, infatti, i risultati delle analisi ci hanno permesso di consigliare delle modifiche nelle procedure attuate, in modo da rendere gli ambienti lavorativi ancora più sicuri”.
La determinazione della carica microbica totale (batteri, muffe e lieviti), sia dispersa in aria che presente sulle superfici di lavoro, è fondamentale per realizzare le necessarie condizioni di sicurezza nella fase di ripresa delle attività lavorative e per valutare l’efficienza degli interventi di sanificazione e di igienizzazione eseguiti.
La carica microbica totale non certifica l’assenza del Coronavirus COVID 19, la cui ricerca ambientale è complessa, ma è uno strumento prezioso per valutare l’efficacia delle tecniche di sanificazione.
I risultati dei test
| Numero di colture eseguite | Numero di colture con cariche batteriche fuori limite | Percentuale di campioni fuori limite | |
| Ufficio non igienizzato | 24 | 12 | 50% |
| Ufficio igienizzato quotidianamente | 40 | 3 | 7,5% |
Per ulteriori informazioni: www.pasalabs.eu www.covid.unitedspa.it
La dottoressa Gussoni è disponibile per chiarimenti e commenti ai risultati.
© United Risk Management
21 Maggio 2020